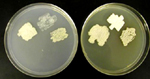

Carvão comum (Bolha) (Morrão do milho, pt)
Ustilago maydis (= Ustilago zeae)
Milho (Zea mays), teosinte (Zea mexicana)
O carvão comum (morrão, pt) do milho, causado por Ustilago maydis, é facilmente identificado pelas galhas tumorosas formadas em tecidos do hospedeiro em ativo crescimento e que contêm uma massa escura, fuliginosa, de teliosporos. Ao redor de quase todo o mundo, o carvão comum (morrão, pt) é considerado uma doença problemática do milho, mas na região central do México, as galhas das espigas são consideradas finas iguarias comestíveis conhecidas lá como cuitlacoche (huitlacoche). Além da significância prática de ser uma doença prevalente e ser um fungo comestível, U. maydis também tem sido usado como modelo para o estudo de vários fenômenos biológicos.

Carvão comum (Morrão, pt) do milho causado por Ustilago maydis (Cortesia de J.K. Pataky).
Palavras chave: bolha do milho, carvão comum, carvão do milho, morrão do milho, cuitlacoche, huitlacoche, cogumelo do milho, Ustilago maydis, Ustilago zeae
Sintomas e Sinais
Ustilago maydis infecta dois hospedeiros: milho (Zea mays) e teosinto (Zea mexicana). Como em outros carvões (morrões, pt), o carvão comum (morrão, pt) do milho tem seu nome derivado de massas fuliginosas de teliosporos encontradas nas plantas infetadas (Figura 2). Os sintomas mais óbvios são galhas tipo tumorosas que variam em tamanho de menos de 1 cm a mais de 30 cm de diâmetro. Todos os tecidos meristemáticos são suscetíveis. As galhas são encontradas com mais frequência na espiga, pendão, colmos, brotos nodais e nervura central das folhas (Figuras 3-6). Muito embora as galhas sejam formadas em muitos locais da parte aérea da planta, a infecção é local (i.e., o hospedeiro não é colonizado sistemicamente). Ocasionalmente, as galhas podem ser formadas abaixo da superfície do solo, quando o meristema apical de uma planta jovem é infetado.

Figura 2 |

Figura 3 |

Figura 4 |

Figura 5 |

Figura 6 |
As galhas do carvão (morrão, pt) consistem de tecidos do fungo e do hospedeiro. Galhas jovens são brancas, firmes e cobertas por periderme semibrilhante. À medida que as galhas começam a maturar, o interior se torna mais macio e com listas de tecido escuro pela formação dos teliosporos. Com o avanço do processo de maturação, as galhas se transformam numa massa pulverulenta de teliosporos e a periderme se rompe liberando-os (Figuras 2 e 3). As galhas normalmente se tornam aparentes dentro de 10 a 14 dias da infecção. Nas espigas, as galhas amadurecem cerca de três semanas após a infecção dos ovários. Grãos levemente descoloridos ou desfigurados se tornam óbvios 3 a 6 dias após a infecção (Figura 7). Pequenas galhas brancas, firmes, se desenvolvem 9 a 10 dias, as quais começam a aumentar resultando num crescimento tumorugênico em 11 a 12 dias após a infecção (Figura 8). As galhas começam a mudar para acinzentadas a prateadas quando listas (?) de tecidos negros (teliosporos) se formam 14 a 15 dias após a infecção (Figuras 9a, b e c). Aproximadamente 70 % do tecido das galhas retém a integridade dos tecidos semimacios, tipo cogumelos, 16 a 18 dias depois da infecção (Figuras 10a e b). Aos 21 a 23 dias da infecção, a periderme se rompe e as galhas se tornam uma massa de teliosporos de má aparência e úmida. Com a desidratação, as galhas apresentam uma aparência fuliginosa e pulverulenta.

Figura 7 |

Figura 8 |

Figura 9a |

Figura 9b |

Figura 9c |

Figura 10a |

Figura 10b |
O número, tamanho e localização das galhas dependem da idade da planta na época da infecção. Galhas em folhas diferem amplamente em tamanho, mas normalmente são pequenas quando comparadas com aquelas em colmos e espigas. Galhas com 20-30 cm de diâmetro são comuns em colmos. Brotos rudimentares abaixo da espiga fértil são comumente infetados. Galhas podem substituir a maior parte do pendão ou flores individuais dependendo da época e severidade da infecção (Figura 5). Galhas na espiga geralmente resultam da infecção individual de ovários. Comumente, alguns grãos na base ou ponta da espiga são infetados (Figura 11), muito embora quase todo grão da espiga possa ser substituído por galhas do carvão (morrão, pt) se a maioria dos ovários for infetada.
Sintomas do carvão (morrão, pt) do topo do milho, causado por Sphacelotheca reiliana, são relativamente semelhantes ao carvão comum (morrão do milho, pt) (Figura 12). O carvão do topo ocorre quando as plantas são infetadas sistemicamente por S. reiliana. As estruturas florais (pendão e espiga) são convertidas em soros contendo massas de teliosporos pulverulentos que se assemelham a galhas maduras do carvão comum (morrão, pt) do milho. Os tecidos vasculares do hospedeiro normalmente estão presentes como estruturas filamentosas nos soros de S. reiliana.

Figura 11 |

Figura 12 |
Biologia do patógeno
Ustilago maydis (= Ustilago zeae) é agrupado taxonomicamente no grupo de fungos dos heterobasidiomicetos. O ciclo de vida de U. maydis inclui três estágios distintos. Os teliosporos diploides são formados nas galhas no hospedeiro infetado e são propágulos de resistência do fungo que sobrevivem em condições rudes invernais. São esféricos a elipsóides, de cor marrom (castanha, pt) olivácea a negra e altamente equinulados, i.e., cobertos por minúsculos espinhos (Figura 13). Quando o teliosporo germina, forma-se o promicélio septado, advém a meiose e formam-se esporídios haploides (também chamados de basidiósporos) que geralmente têm um único núcleo (Figura 14). Os esporídios haploides são facilmente mantidos em meio de cultura, estágio considerado por muitos como a fase saprofítica do fungo. Culturas de esporídios podem ser propagadas em vários meios de cultura onde elas apresentam variação considerável em morfologia, cor, tamanho e crescimento (Figura 15). Os esporídios não infecciosos se fragmentam por gemação de forma semelhante à levedura (Figura 16). Sob condições ambientais apropriadas, esporídios geneticamente compatíveis se cruzam e formam hifas dicarióticas infectivas; as células neste terceiro estágio são patogênicas e podem infeccionar milho e teosinto.

Figura 13 |

Figura 14 |
Figura 15 |

Figura 16 |
Detalhes adicionais sobre a biologia de Ustilago maydis
Cruzamento e infecção estão sob o controle genético de dois locos diferentes, a e b. Historicamente, a tem sido chamado de loco de cruzamento e b de patogenicidade. Para que U. maydis cause infecção, parceiros de cruzamento (i.e., esporídios haploides que formam hifa dicariótica) devem obrigatoriamente ter alelos diferentes em ambos os locos a e b (por exemplo, um esporídio com os alelos a1b2 cruzará com outro que tenha os alelos a2b1). Esses alelos já foram clonados e sequenciados. O loco a tem dois alelos, a1 e a2 e codificam componentes de uma rota de resposta a feromônios que media a formação de tubos de conjugação e fusão celular. Quando há limitação de nutrientes, esporídios haploides de diferentes alelos no loco a formam finos filamentos que crescem um em direção ao outro seguindo gradientes de feromônios. No final, os filamentos se fundem. Alelos múltiplos no loco b ocorrem, os quais codificam proteínas de ligação ao DNA, com funções regulatórias. Se o produto dicariótico resultado da fusão dos filamentos tiver dois núcleos diferentes no loco b, forma-se um vigoroso filamento infectivo (Figura 17). O filamento infectivo responde à superfície específica do hospedeiro formando um apressório que permite a penetração do fungo no hospedeiro (Figura 18). Os apressórios são formados somente em células vivas em processo de rápido crescimento. Ainda não se conseguiu a indução de apressórios in vitro. O cruzamento e penetração ocorrem num lapso de 12-18 horas em plantas inoculadas artificialmente com esporídios compatíveis.

Figura 17 |

Figura 18 |
Nos primeiros vários dias da infecção, os tecidos infetados podem parecer levemente cloróticos, mas existem alguns sinais macroscópicos da infecção. Exames microscópicos revelam que nos estágios iniciais, o dicarionte de U. maydis se comporta como biotrófico. As hifas crescem intracelularmente, mas ambas as membranas plasmáticas do fungo e do hospedeiro permanecem intatas. As células da planta mantém o fluxo citoplasmático normal mesmo estando invadida pela hifa (Figura 19). Haustórios regulares não são observados, porém a presença de uma massa eletrodensa entre as paredes do hospedeiro e fungo é provavelmente o local de transferência de nutrientes (Figura 20). A natureza exata dos nutrientes transferidos é desconhecida, porém a maioria das estirpes de U. maydis auxotróficos para aminoácidos é não patogênica, sugerindo que carboidratos simples possam ser o nutriente primário usado pelo fungo.

O arquivo é a.MOV e pode ser necessário
um leitor de filme no seu navegador para tocar.
Pode baixar download Quicktime
se precisa de um leitor.
|

Figura 20 |
Alterações microscópicas tais como aumento anormal de células parenquimáticas, podem ser vistas dentro de 24 horas após a inoculação. Tumores resultantes do crescimento anormal das células do hospedeiro começam a se desenvolver dentro de uma semana da inoculação. Estes são inicialmente resultado da divisão celular anormal e aumento do tecido do hospedeiro, onde raramente se observa a presença de hifas. As células do hospedeiro permanecem vivas durante os primeiros estágios de formação do tumor, continuando seu crescimento e divisão, porém cessa o desenvolvimento normal dos tecidos. Por exemplo, se se perde o padrão normal das nervuras e células parenquimáticas podem se tornar extremamente grandes. À medida que o tumor cresce, as hifas começam a proliferar mais entre do que dentro das células do hospedeiro (Figura 21). A cariogamia (i.e., fusão nuclear que ocorre na reprodução sexual) parece ocorrer nos estágios iniciais de formação do tumor e é seguida rapidamente pela proliferação de hifas entre as células do hospedeiro. Neste estágio, as paredes das hifas se tornam inchadas e gelatinosas e o protoplasma perde sua forma cilíndrica, tornando-se esférico. Por processos pouco compreendidos, o ponto inicial de formação dos esporos aumenta e desenvolvem-se as paredes pigmentadas e ornamentadas dos teliosporos, os quais podem ser vistos emergindo das hifas gelatinizadas remanescentes (Figura 22). O fungo completa seu ciclo cada vez que teliosporos são formados no hospedeiro atacado.

Figura 21 |

Figura 22 |
Ciclo da Doença e Epidemiologia
 Disease Cycle
Disease CycleEpidemiologia
No final do século 19, Brefeld elaborou muito os detalhes do ciclo do carvão comum (morrão, pt) que coincide com o ciclo de vida de U. maydis. O fungo sobrevive a condições adversas de inverno como teliosporo diploide nos restos culturais ou solo. Christensen estimou que uma galha de tamanho mediano possa conter mais de 200 bilhões (milhares de milhões, pt) de esporos (Figura 23). Os teliosporos podem manter-se viáveis por vários anos. Os teliosporos podem ser disseminados diretamente pelo vento ou respingos de chuva, ou podem germinar, sofrer meiose para formar esporídios haploides que são também disseminados pelo vento ou respingos de chuva. Os esporídios germinam de forma semelhante à levedura, cruzam e formam hifa dicariótica infectiva. Hifas infectivas de estirpes compatíveis (por exemplo, alelos diferentes nos locos a e b) penetram e infeccionam o hospedeiro. Toda a infecção é local. Qualquer porção da parte aérea da planta pode ser infetada, particularmente tecidos meristemáticos em crescimento ativo. O fungo pode também crescer dentro do estigma (cabelo (barbas, pt) do milho) e dentro do ovário em desenvolvimento (grão), resultando nas galhas da espiga. Cada galha numa espiga infetada representa a infecção de um ovário individual. Tecidos desfigurados que se transformam em galhas podem ser notados dentro de dias após a infecção. As galhas se formam dentro de sete dias e crescem até 3 semanas depois da infecção. Cerca de 1 a 2 semanas pós-infecção, as hifas nas galhas começam a gelatinizar e suas células tornam-se arredondadas e formam-se as paredes celulares dos teliosporos. As galhas amadurecem e desidratam, a periderme se rompe e os teliosporos são liberados.

Figura 23 |
Os teliosporos produzidos nas galhas de tecidos infetados provavelmente não são importante como fonte de inóculo na safra onde são formados. Contudo, são fontes de inóculo que sobrevive o inverno e que iniciam as infecções na safra seguinte. Parece haver na natureza inóculo suficiente que resulta em tanto carvão comum (morrão, pt) quanto plantas hospedeiras e que as condições ambientais sejam favoráveis. Em alguns casos, o carvão comum (morrão, pt) ocorreu em campos recém-abertos e que nunca haviam sido usados com a cultura do milho.
Não existe consenso sobre as condições que são mais favoráveis para o carvão comum (morrão, pt), embora muitos relatos indicam que a doença é prevalente em condições climáticas com chuva e umidade. Também existem relatos ligando o aumento da taxa de infecção com ferimentos nas plantas, como ocorre no despendoamento. Galhas em folhas e colmos de plântulas são frequentemente observadas a seguir a pesadas chuvas com ventos fortes, especialmente quando as plantas são feridas com partículas de solo. Obviamente, a germinação e disseminação dos teliosporos e/ou esporídios são favorecidas por vento e chuva. Portanto, qualquer coisa que induza rapidamente divisão e elongação celular localizada, tal como ferimentos, pode aumentar a suscetibilidade à infecção. Fatores que reduzem a formação de pólen ou inibem a polinização também aumentam a ocorrência de carvão na espiga porque os ovários se tornam protegidos da infecção de U. maydis tão logo eles sejam fertilizados, muito provavelmente porque após a fertilização o estigma morre e não é mais suscetível à infecção. Por exemplo, condições quentes e de seca causam assincronia entre a produção de pólen e a emergência dos estigmas resultando em fraca polinização. Galhas nas espigas podem se tornar prevalentes se U. maydis for prontamente disseminado nos estigmas de ovários não fertilizados durante ou logo após as condições quentes e de seca. Assim, associa-se a ocorrência de galhas nas espigas sob condições de seca, embora essas condições provavelmente induzem a prevalência de galhas na espiga primeiramente pelo aumento do número de ovários não polinizados e com rápido crescimento dos estigmas.
Manejo do (Meios de Luta para o, pt) Carvão Comum do Milho (Morrão do milho, pt)
Manejo (Meios de Luta, pt)
Muitos métodos para o controle do carvão comum têm sido recomendados ou avaliados incluindo rotação de culturas, medidas sanitárias, tratamento de sementes, fungicidas foliares, modificação da fertilidade e controle biológico. A despeito dessas táticas de controle frequentemente mencionadas, a resistência genética é o único método prático de controle em áreas onde U. maydis seja prevalente. Todavia, nenhuma linhagem de milho é imune à infecção de U. maydis.
Resistência
O primeiro avanço significativo no controle do carvão comum (morrão, pt) ocorreu quando adveio a primeira geração de milho híbrido obtida com linhagens selecionadas para baixa incidência de carvão (morrão, pt). Muito embora a resistência ao carvão comum (morrão, pt) seja estudada há quase 100 anos, os mecanismos de resistência e genes que condicionam resistência não têm sido claramente documentados.
Antigos melhoristas (melhoradores, pt) de milho observaram que as variedades do tipo grão duro eram mais suscetíveis do que as de grão dentado. Em 1918, apenas uma década após a descoberta independente por George Shull e Edward East, da heterose (vigor híbrido) Donald Jones e East demonstraram na Estação Experimental de Connecticut que linhagens autofecundadas diferiram muito no número de plantas infectadas por carvão (morrão, pt). Durante os próximos 10 anos, melhoristas (melhoradores, pt) de milho daquela época, como H.K. Hayes, R.J. Garber e F.R. Immer anunciaram que linhagens autofecundadas originárias de populações de polinização aberta de milho resultavam em rápido avanço de linhagens com notáveis diferenças quanto à reação ao carvão (morrão, pt). Não só as linhagens diferiam na incidência do carvão (morrão, pt), mas as linhagens suscetíveis diferiam quanto ao local de formação das galhas na planta. Por exemplo, algumas linhagens eram uniformemente infetadas nos entrenós baixeiros enquanto outras tinham alta incidência no pendão. A rapidez com que linhagens autofecundadas se tornavam homogêneas para reação ao carvão comum (morrão, pt) levou Immer e J.J. Christensen a especularem que “um número relativamente pequeno de fatores genéticos estão envolvidos na determinação das reações” e que “cruzamentos compostos (de linhagens resistentes ao carvão (morrão, pt)) produzirão, sem dúvida, linhagens resistentes em altas percentagens.” Afortunadamente, a última das hipóteses se mostrou correta.
Em 1928, Marion Griffiths, uma fitopatologista do USDA, demonstrou que linhas autofecundadas de milho e cruzamentos entre elas e que eram resistentes à infecção natural por U. maydis no campo se mostraram muito suscetíveis após inoculação artificial. Nenhuma linhagem se mostrou resistente quando Griffiths usou uma agulha para injetar a suspensão de esporídios de U. maydis em tecidos de plantas jovens. Ela propôs a hipótese de que “resistência ou suscetibilidade é grandemente o caso da relativa facilidade de acesso de partes suscetíveis (da planta) ao organismo invasor.” Outros pesquisadores logo começaram a corroborar com as observações de Griffiths demonstrando que a proteção de tecidos suscetíveis por não suscetíveis tinha grande importância na resistência ao carvão (morrão, pt). Após observar uma estreita relação entre suscetibilidade ao carvão (morrão, pt) e a condição de maior ou menor abertura das gemas apicais (i.e., a firmeza das folhas do cartucho), A.H. Eddins concluiu que “gemas apicais abertas seguram o inóculo e permitem que a suspensão (de esporos) escorra para dentro da planta e fique em contato com tecidos suscetíveis novos e em franco crescimento”.
J.M. Walter e outros observaram que o aparecimento de galhas, em folhas e colmos feridos, ou no ferimento devido ao despendoamento, foi em maior incidência, embora as galhas de carvão (morrão, pt) não ocorressem diretamente nas injúrias, mas em tecidos próximos a elas. Após a avaliação de 200 linhagens autofecundadas plantadas em condições de epidemia de carvão por dez anos e em cruzamentos entre elas, e testemunhas com ligações genéticas, M.M Hoover concluiu que as reações ao carvão estavam condicionadas por dois conjuntos de fatores genéticos: um controlando o comportamento fisiológico e outro relacionado com a morfologia bruta da planta.
Nos idos da década de 1940 quando híbridos duplos estavam começando a serem cultivados em quantidades significativas das áreas de produção de milho nos Estados Unidos, os melhoristas (melhoradores, pt) da cultura tinham avançado substancialmente na resistência ao carvão simplesmente selecionando contra suscetibilidade nas populações e linhagens. Quando G.H. Stringfield e D.H. Bowman compararam a incidência de carvão (morrão, pt) em 340 variedades de polinização aberta e em 1.052 híbridos em 48 experimentos em todo o Estado de Ohio de 1933 a 1938, eles observaram que 75% dos híbridos tinham menos carvão (morrão, pt) que as variedades de polinização aberta (Figura 24). Híbridos derivados de 12 linhagens as quais Stringfield considerava resistentes ao carvão (morrão, pt), tinham menos de um terço de carvão que as cultivares de polinização aberta. Esse tipo de progresso, resultando na seleção contra a suscetibilidade ao carvão (morrão, pt) sem o conhecimento sobre genes específicos de resistência envolvidos ou os mecanismos de resistência, continua até os dias de hoje. A maioria dos híbridos modernos de milho cultivados nos Estados Unidos tem níveis adequados de resistência à infecção natural para evitar epidemias catastróficas. Todavia, não se conhece nenhum híbrido imune à infecção quando se inocula com uma suspensão de esporídios e não se identificou genes maiores responsáveis pela resistência, a despeito das avaliações atuais do mapeamento de locos quantitativos para resistência ao carvão nas populações de milho.

Figura 24 |
Híbridos de milho doce, nos quais tem em seus pedigrees o germoplasma do milho duro de New England, tendem a ser mais suscetíveis ao carvão (morrão, pt) do que o milho comum. Isto pode ser devido às diferenças no background genético entre o milho comum e o doce e/ou diferenças nos cuidados com que as linhagens suscetíveis do milho comum e do doce foram eliminadas nos programas de melhoramento. Galhas na espiga são as de maior importância econômica no milho doce. Conclusões semelhantes às tiradas pelos melhoristas (melhoradores, pt) e fitopatologistas dos anos 20 e 30, sobre a associação entre a morfologia bruta da planta e a reação das linhas de milho ao carvão (morrão, pt), a resistência a galhas de espiga poderia ser morfológica ou fisiológica. K.M. Snetselaar e colaboradores demonstraram recentemente os que ovários (grãos) estão protegidos contra a infecção por U. maydis quando a camada de abscisão se forma na base do estigma logo após a fertilização (i.e., polinização). A rapidez com que a camada de abscisão se forma, a taxa de crescimento do tubo germinativo do pólen, a sincronização entre emergência do estigma e produção de pólen e a altura da espiga (assumindo que o inóculo se dispersa a partir do solo) são apenas alguns dos fatores morfológicos que permitiriam as plantas de milho escapar a infecção de espiga e parecer ter “resistência de campo”.
Erradicação e exclusão
Embora Ustilago maydis ocorra no mundo todo onde milho é cultivado, na Austrália sua presença é localizada, onde a doença é conhecida como carvão (morrão, pt) da bolha do milho. Por quase todo o século 20, os australianos tentaram excluir U. maydis de áreas onde ele não ocorria. Lavouras atacadas eram destruídas para erradicar ocorrências de U. maydis e medidas quarentenárias foram forçadas para excluir novas introduções.
Em 1911, quando o carvão comum (morrão, pt) foi reportado pela primeira vez em Bathurst, New South Wales, Austrália, a área infetada foi destruída e por 10 anos não foi plantado milho naquela fazenda. A doença permaneceu localizada naquela área, recorrendo esporadicamente entre 1935 e 1940. Áreas afetadas foram destruídas e medidas quarentenárias foram tomadas proibindo o plantio de milho por 25 anos. Também, áreas livres da doença podiam ser plantadas com milho somente com sementes advindas de áreas livre de U. maydis e tratadas com fungicidas aprovados. Esse foi considerado um caso bem sucedido de erradicação e exclusão porque não se reportou novos casos de ocorrência do carvão comum até 1982 quando a doença foi detectada em todo o distrito de North Coast de New South Wales e sudoeste de Queensland (Figura 25). Em 1996, a doença se espalhou para outras áreas desta região e cruzou a cadeia de montanha Great Dividing onde se espalhou para o sul em áreas a oeste de Sidney. Subsequentemente, a doença foi reportada em áreas ao sul de New South Wales onde milho é produzido sob irrigação e pelo menos em um local ao norte de Victória. De acordo com companhias australianas de sementes, o carvão (morrão, pt) da bolha do milho continua se espalhando para áreas próximas a Bathurst, Dubbo e no distrito irrigado de Murrimbigee.

Figura 25 |
Significância
Significância econômica
Perdas econômicas têm sido relativamente pequenas nos campos de milho nos Estados Unidos desde inícios dos anos de 1940, quando houve ampla adoção de híbridos e o nível de resistência melhorado drasticamente. Todavia, a produtividade pode ser reduzida ocasionalmente caso o carvão comum (morrão, pt) esteja prevalente e severo. As perdas são máximas quando o meristema apical de plântulas muito jovens é infetado no que resulta em plantas mortas ou improdutivas. Galhas na espiga também podem ser economicamente importantes em milho comum dependendo da severidade da infecção (i.e., número de grãos da espiga substituídos por galhas). Economicamente, explosões significativas de carvão (morrão, pt) em campos de milho comum normalmente estão associadas com severas tempestades ocorridas logo após emergência ou em plantas sob estresse (por exemplo, seca) que resulta em assincronia da emergência dos cabelos (das barbas, pt) do milho e produção de pólen. Antes do desenvolvimento do milho híbrido, as perdas devido à ocorrência do carvão comum (morrão, pt) foram estimadas a variar até 10% anualmente porque a doença, em algumas ocasiões, era bastante prevalente. Por exemplo, a incidência de plantas infetadas foi de 6% a 18% quando campos de milho próximo a Ames, Iowa, foram amostrados de 1930 a 1934. Outras ocorrências de mais de 75% de incidência de carvão (morrão, pt) em variedades de polinização aberta foram reportadas ocasionalmente antes da criação dos híbridos.
O carvão comum (morrão, pt) é mais importante economicamente em milho doce do que em milho comum. Quando o milho doce destina-se ao mercado fresco (por exemplo, bancas ao longo de rodovias, mercado de produtores, sacolões), espigas com uma única galha usualmente não é aceita no mercado pela “injúria cosmética” (i.e., falta de aceitação pelo consumidor). E por isso, mesmo uma baixa incidência de carvão comum (morrão, pt) pode significar perda substancial. Quando o milho doce é produzido para a indústria de enlatados (i.e., conservas, congelados), campos com quantidades moderadas de galhas na espiga não são colhidos. No mercado para venda in natura e em lavouras para processamento, galhas em outras partes da planta podem causar perdas secundárias se a lavoura é colhida mecanicamente porque a palha das espigas se torna coberta por teliosporos (Figura 26). Em lavouras para processamento, custos adicionais decorrem para a remoção dos teliosporos contaminantes da palha das espigas. No mercado in natura, alguns consumidores rejeitam a espiga com aparência encarvoada, mesmo que as espigas não apresentem danos.

Figura 26 |
Em áreas no mundo onde variedades de polinização aberta são cultivadas, ou onde os híbridos são desenvolvidos com germoplasma suscetível, o carvão comum continua sendo problemático. Por exemplo, a incidência de infecção de carvão atingiu mais de 50% em 1976 em várias áreas da Alemanha onde prevaleciam híbridos derivados de milho duro europeu.
Organismo modelo para estudos biológicos básicos
Ustilago maydis tem sido usado por pesquisadores como um organismo modelo para estudar fenômenos biológicos interessantes, incluindo compatibilidade fúngica, dimorfismo fúngico, interações patógeno-hospedeiro e recombinação genética e reparações. Uma característica intrigante no seu ciclo de vida é que apresenta os dois estágios biotrófico e saprofítico. Outras características que o faz um organismo particularmente atrativo inclui: a) a fase saprofítica é haploide e, portanto, facilmente manipulável geneticamente, b) a progênie meiótica é facilmente analisada, c) o ciclo total de vida pode ser completado em plantas jovens em aproximadamente 3 semanas, e d) estirpes diploides podem ser construídas artificialmente no laboratório. Alguns exemplos desses estudos podem ser mencionados aqui.
Nos anos 60 e 70, R. Holliday baseado em trabalhos de pesquisadores anteriores cuidadosamente desenvolveu meios e técnicas padronizados para trabalhar com U. maydis. Ele também produziu uma impressionante gama de mutantes de vários tipos. Alguns deles eram especialmente suscetíveis a mutações adicionais, porque tinham defeitos em suas capacidades de reparação do DNA. Holliday usou esses mutantes para desenvolver um modelo para ver o quanto de homologia pode ocorrer entre moléculas pareadas de DNA. A “estrutura de Holliday” e o Modelo de Holliday de recombinação genética estão virtualmente descritos em todos os livros texto de genética. O trabalho sobre recombinação continua a trazer frutos, muito notavelmente no laboratório de W. Holloman. Mulheres com mutações herdadas de um gene supressor de tumor humano conhecido como BRCA2 têm mais tendência a desenvolver câncer de seio e ovário, comparadas com mulheres sem as mutações. Pesquisadores do laboratório de Holloman descobriram o homólogo de BRCA2 em U. maydis, e foram capazes de mostrar como os produtos desse gene supressor estão envolvidos na reparação do DNA danificado.
Os sistemas de compatibilidade de cruzamento em basidiomicetos filamentosos são caracterizados por alelos múltiplos em dois locos genéticos; estirpes com alelos desiguais em ambos os locos são ditos como compatíveis e podem cruzar e começar o desenvolvimento sexual. A multiplicidade de possíveis combinações de alelos tem fascinado cientistas que estudam cogumelos e outros basidiomicetos por muitos anos, mas as interações moleculares não eram compreendidas até bem recentemente. A compatibilidade sexual em U. maydis foi bem descrita por Christensen e pesquisadores anteriores e é fácil avaliar a compatibilidade sexual com isolados haploides usando-se um método com ágar-carvão descrito primeiramente por Day e Anagnostakis (Figura 27). No final dos anos 80 e início dos 90, S. Leong, R. Kahmann e colaboradores aproveitaram trabalhos anteriores e, com o fato de que U. maydis era facilmente produzido como levedura haploide em meio líquido, eles desenvolveram e usaram um sistema de transformação genética que os permitiu clonar e descrever genes de compatibilidade sexual em U. maydis. A presença da combinação feromônio-receptor em um loco acoplado com um regulador transcriptacional em outro loco, primeiramente elucidado em U. maydis, é um tema comum em sistemas de cruzamentos em basidiomicetos.

Figura 27 |
Mais recentemente, o genoma inteiro de U. maydis foi sequenciado como parte de uma colaboração internacional. O genoma e suas notificações estão disponíveis publicamente no banco de dados de Ustilago maydis mantido pelo Centro de Informações de Sequencias de Proteínas em Munich (MIPS) e na internet no endereço: http:/mips.gsf.de/projects/fungi/ustilago.html. A disponibilidade da sequencia genômica e de ferramentas correlatas estão começando a dar frutos para os cientistas interessados nas interações patógeno-hospedeiro.
Cuitlacoche: galhas comestíveis de Ustilago maydis
Cuitlacoche (ou huitlacoche) é um nome nativo mexicano dado às galhas jovens, comestíveis que se formam quando espigas de milho são infectadas por Ustilago maydis. No México central, cuitlacoche é uma iguaria muito valorizada que tem sido comida desde tempos pré-colombianos. Produtores tradicionais de milho colhem e mercantilizam cuitlacoche oriundo de infecção natural. Cerca de 400 a 500 toneladas de cuitlacoche são comercializadas anualmente durante os meses de julho e agosto nos mercados da Cidade do México (Figuras 28a-d). Mais de 100 toneladas são processadas por companhias que vendem esse cogumelo especial em conserva ou liofilizado (Figuras 29a, b).

Figura 28a |

Figura 28b |

Figura 28c |

Figura 28d |

Figura 29a |

Figura 29b |
Concomitantemente como o mercado em expansão nos Estados Unidos de outros cogumelos especiais tais como Pleurotus (ostra), Lentinula (shiitake), Flammulina (enoki) e Morchella (morelas), epicureanos na América do Norte cada vez mais vêm o cuitlacoche como um “cogumelo” gourmet que faz parte do crescente mercado para alta cozinha mexicana. Cuitlacoche é servido em sopas, aperitivos e entradas em muitos restaurantes mexicanos da moda, nas grandes áreas metropolitanas nos Estados Unidos, tais como Topolobampo, em Chicago e Rosa Mexicano em Nova Iorque e Washington, capital (Figuras 30a–c). Receitas de preparo do cuitlacoche estão disponíveis na internet e em livros de receitas gourmet mexicanos, tais como Rick Bayless’s Mexican Kitchen e a Arte da Cozinha Mexicana de Diana Kennedy. Conservas de cuitlacoche são vendidas pela internet e algumas vezes são chamadas de “cogumelo do milho” ou “trufas mexicanas”. Cuitlacoche fresco ou congelado estão ocasionalmente disponíveis nos mercados de produtores ou em lojas locais de suprimentos nos Estados Unidos (Figuras 31a-c).

Figura 30a |

Figura 30b |

Figura 30c |

Figura 31a |

Figura 31b |

Figura 31c |
Métodos de cultivo de cuitlacoche como uma cultura de valor e vários outros aspectos do sistema de produção de cuitlacoche tem sido estudados nos Estados Unidos e no México durante os últimos 15 anos. Aspectos essenciais do cultivo eficiente de cuitlacoche incluem: métodos eficientes de inoculação, taxas de crescimento de galhas e de formação de teliosporos, época ótima para inoculação e colheita, práticas de produção que otimize a infecção, tamanho da galha e produtividade e, possivelmente mais importante, manejo pós-colheita e mercado.
Referências Selecionadas
Banuett, F. 1995. Genetics of Ustilago maydis, a fungal pathogen that induces tumors in maize. Annual Review of Genetics 29:179-208.
Bayless, R., D.G. Bayless, and J.M. Brownsen. 1996. Rick Bayless's Mexican Kitchen. Scribner, New York. 448 pp.
Christensen, J.J. 1963. Corn smut caused by Ustilago maydis. American Phytopathological Society Monograph 2. 41 pp.
Day, P.R., and S.L. Anagnostakis. 1971. Corn smut dikaryon in culture. Nature: New Biology 231:19-20.
Kahmann, R., and J. Kämper. 2004. Tansley Review: Ustilago maydis: How its biology relates to pathogenic development. New Phytologist 164:30.
Kennedy, D. 1989. The Art of Mexican Cooking: Traditional Mexican Cooking for Aficionados. Bantam Books. New York. 526 pp.
Pataky, J. K. and M. A. Chandler. 2003. Production of huitlacoche, Ustilago maydis: timing inoculation and controlling pollination. Mycologia 95:1261-1270.
Snetselaar, K.M., M. Carfioli, and K.A. Cordisco. 2001. Pollination can protect maize ovaries from infection by Ustilago maydis, the corn smut fungus. Canadian Journal of Botany 79:1390-1399.
Wang, J., D.W. Holden, and S.A. Leong. 1988. Gene transfer system for the phytopathogenic fungus Ustilago maydis. Proceedings of the National Academy of Science 85:865-869.
Yang, H., Q. Li, J. Fan, W. Holloman, and N. Pavletich. 2005. The BRCA2 homologue Brh2 nucleates RAD51 filament formation at a dsDNA-ssDNA junction. Nature 433:653-657.
Conexões com páginas da Internet
The MIPS Ustilago maydis Genome DataBase
http://mips.helmholtz-muenchen.de/genre/proj/ustilago
Saint Joseph's University Ustilago Research Page
http://www.sju.edu/biology/ksweb/ustilago/intro.html
Broad Institute Ustilago maydis data base
http://www.broad.mit.edu/annotation/fungi/ustilago_maydis/
Various recipes for cuitlacoche
http://www.sweetcorn.uiuc.edu/Common-smut/Recipes.htm
